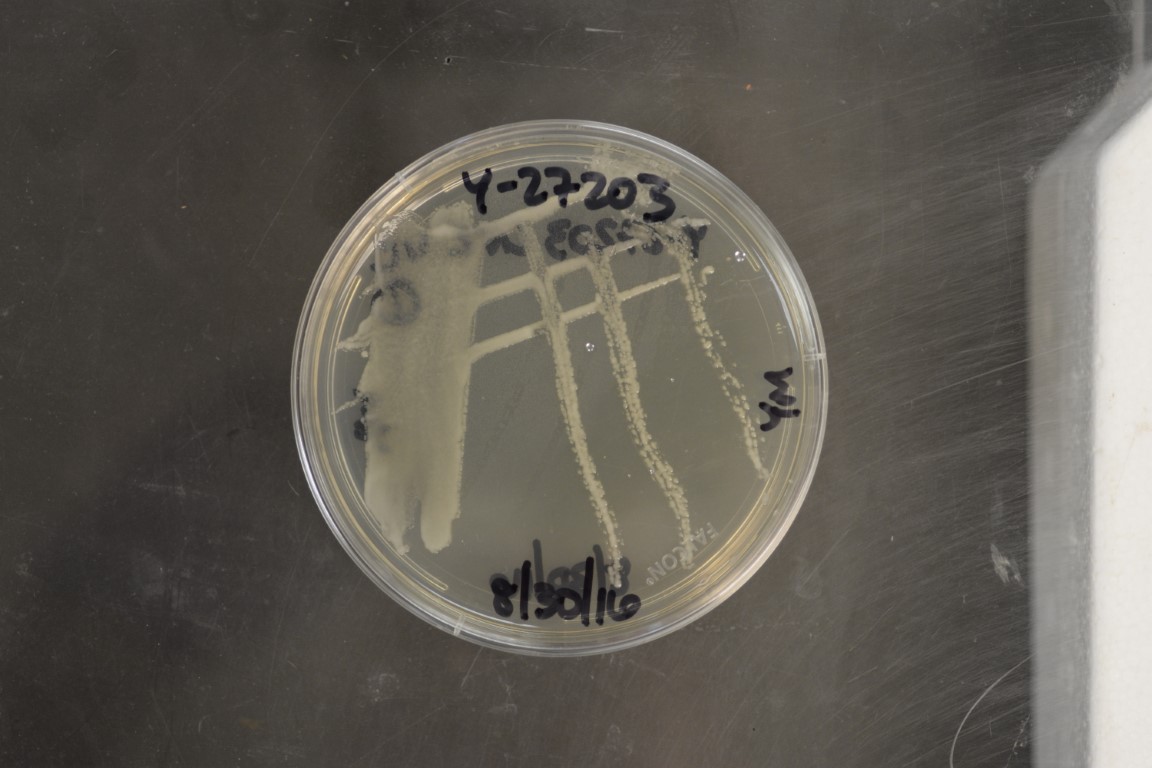

Kazachstania bulderi
NRRL Y-27203(Type Strain)
Accession numbers in other collections:CBS 8638=DBVPG 7127=JCM 31689=Middelhoven G8
Source:W.Middelhoven,Dept.of Microbiology,Wageningen,The Netherlands
Isolated from(substrate):SI,maize silage
Substrate location:Lelystad,The Netherlands
Genetic info:Robnett PCR#A212,A467-Special;0 diff.D1/D2 and ITS with Y-27204;0 diff.D1/D2 and ITS with Y-27205;3 diff.D1/D2 with Y-17918 and Y-27223.GenBank:D1/D2(AF398486),SSU(AY046241).
Growth media:Yeast Extract-Malt Extract-Peptone-Glucose(YM for yeasts)(number 6)
Optimum growth temperature:25C
Strain images:
NRRL_Y-27203_6.JPG